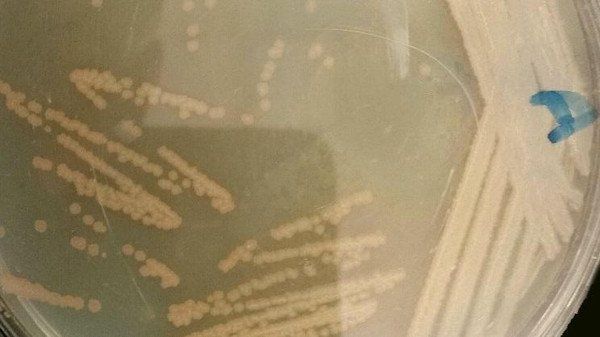

اكشتف باحث في جامعة الملك فهد للبترول والمعادن نوعين جديدين من البكتيريا تعيش في درجات حرارة مرتفعة، حيث تم اكتشافهما لأول مرة في السعودية وذلك بالينابيع الساخنة من منطقة الخوبة والعارضة بجازان حيث تصل درجة الحرارة في هذه الينابيع نحو 70 درجة مئوية.
وقال مكتشف "البكتيريا" الأستاذ المشارك في قسم الأحياء في جامعة الملك فهد الدكتور أمجد خليل إن هذه الأنواع تمتاز في انتاج مجموعة من البروتينات والأنزيمات ذات التطبيقات الصناعية المهمة، مثل الصناعات الغذائية، وصناعة المنظفات والجلود ، وصناعة الورق.
وأضاف أنه تم تحديد هذه السلالات الجديدة باستخدام تقنيات تكنولوجية حديثة من خلال ما يعرف بالتسلسل الوراثي لجينات، والتي تحدد نوع السلالة البكتيرية بدقة عالية جدا بعد مقارنتها بما هو معروف في بنك المعلومات العالمي والمختص بهذا النوع من الأبحاث، حيث تم تعريف هاتين السلالتين بشكل دقيق جدا على أنهما سلالتان جديدتان (Novel bacteria) لم يتم التعرف عليهما من قبل، وهتان السلالاتان هما "Anoxybacillus flavithermus AK1 –و "Brevibacillus borstelensis AK2".
وأكد الدكتور أمجد أنه تم تسجيل هاتين السلالتين في مؤسستين عالميتين في ألمانيا وبلجيكا وهما تعتبران من الجهات العالمية المعتمدة لهذا الغرض، مشيرا إلى أن المؤسستين تقومان بالتحليل الجيني – الموروث - لهاتين السلالتين مرة أخرى في المختبرات الخاصة بهما للتأكيد على أن هاتين السلالتين هما بالفعل من السلالات الجديدة وغير المسجلة من قبل بهما ليقوما بعد ذلك بالإعلان على أن هاتين السلالتين هما بالفعل سلالات جديدة لم يتم اكتشافها من قبل.








